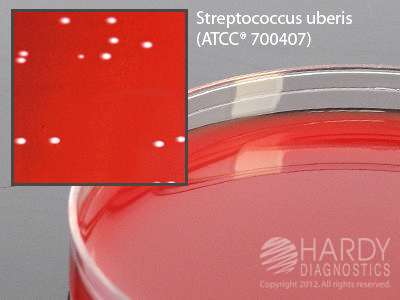

Bovine Blood Agar, 5% , Pack Of 10
$ 34.67
|
|
Details:
Bovine Blood Agar^ Bovine Blood Agar, 5%, for bovine mastitis, 15x100mm plate, for detection of organisms that may cause mastitis in dairy cattle, such as Staphylococcus aureus and Streptococcus agalactiae, pack 10
Additional Information
| SKU | 23531519 |
|---|---|
| UOM | Pack of 10 |
| UNSPSC | 41106200 |
| Manufacturer Part Number | A188 |
| Product Dimensions | 4X4X8 Inches |
| Product Weight | 1 |
